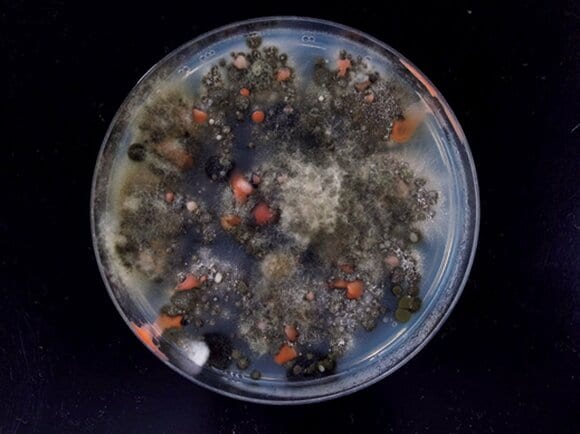
壁からはアレルギーの原因となるクロカビが720個も検出

気温と湿度が上昇する梅雨どきは、カビ・ダニが活発になる季節。
毎日過ごす時間が長いけど、見落としがちなカビ・ダニの発生場所が寝室やクローゼットです。今回、カビ・ダニ博士の川上裕司さんがESSEレポーターのHさんのお宅にお邪魔して、見落としがちな場所を徹底チェックしました。また、その対策を掃除のプロ・高橋敬子さんに教えてもらいました。
梅雨どきはとくに注意!寝室やクローゼットはカビの温床
<本棚>カビが発生すると害虫を呼び寄せ、深刻なアレルギーも
すべての画像を見る(全12枚)まず、本棚をチェックすると、ホコリ1g当たり300匹のチャタテムシ(写真)が。コナヒョウヒダニも333匹検出しました。「どちらもアレルギーの原因になり、見逃せません」と、川上さん。
さらに、寝室の本棚から本を取り出してみると「うっすらホコリがつき、カビの兆候が。本のカビは、ぜんそくを引き起こす『チャタテムシ』を呼ぶ危険が」と川上さんからの警告が。「家族の寝室なので、本棚を別の部屋に移さなきゃ」とHさんは慌てます。
【退治法】
本についた茶色いシミはカビが原因なので、虫がいないかすぐチェックを。虫が発生した本は、外に出してハケなどで十分払います。その後一日陰干ししてからしまってください。
【予防法】
本棚にしまった本は、上部にホコリがたまりやすいので、ブラシ式のノズルをつけた掃除機でしっかり吸い取ります。本棚自体もこまめに掃除する習慣をつけましょう。
<布団>湿気やすく、ダニが大量発生しがち。こまめに天日干しを
汗や髪の毛など栄養源がたっぷりあり、潜みやすいのが布団です。「ダニが好む場所の代表格。ひと晩じゅう顔や体が触れるので、ダニ対策はマスト」と川上さん。
定期的な天日干しはもちろん、ダニの死骸も掃除機で残さず吸い取ることが必要になります。
【退治法】
布団は4~5時間以上、天日干しにしたあと、表面に掃除機を丁寧にかけます。布団専用ノズルを使うのがベストですが、ない場合はヘッドに生ゴミ用のネットをかぶせてもいいでしょう。
【予防法】
朝起きたら布団はすぐにしまわず、イスなどにかけ、湿気を飛ばしてから押し入れへ。定期的な天日干しも習慣にし、シーツや枕カバーをこまめに洗濯することも大切です。
<ベッドの下>綿ボコリはダニのすみか。寝具にカビがつくことも
ベッドの下の綿ボコリは、ダニの生息ゾーン。
「空気がよどむとさらに増殖することに。下にはものを置かず、通気性を確保して」(川上さん)
ベッド回りが湿気るとベッドマットなどにもカビがつく危険もあるので注意です。
【退治法】
ベッドを動かし、壁際にたまったホコリも残さず掃除機で吸い取ります。ベッドマットやベッドの底板についたカビは、布+消毒用エタノールで押さえるようにして殺菌します。
【予防法】
ベッドの下は収納ボックスなどを置かず、掃除がしやすい環境に。北向きの寝室では、ベッドの壁側がカビやすくなるので、ベッドマットの位置を定期的に変えるといいでしょう。
<窓>サッシ回りにカビがつきがち。こまめな殺菌で予防を
「サッシにホコリがたまるとカビが増殖。結露しやすい北向きの部屋はとりわけ注意が必要です」とは川上さん。ホコリや水滴は放置せずにケアが必要です。消毒用エタノールでこまめに殺菌するのもおすすめです。
【退治法】
サッシのパッキンに生えたカビは、カビ取り剤で除去。ティッシュペーパーでこよりをつくり、パッキンの溝にはめ、カビ取り剤をスプレーするか、ジェル状のカビ取り剤を直接塗って除去します。
【予防法】
掃除のときは、サッシ回りのホコリも忘れずにふき取ります。結露がついているときは、朝のうちに窓ガラスの水滴やサッシの水分をふき取ってください。
<カーテン>ホコリっぽいカーテンはカビ・ダニの隠れ家に
布製カーテンはホコリを吸着させ、想像以上に汚れているもの。「結露しやすい窓にかけている場合は、カーテンにも湿気が移り、カビ・ダニの危険が増すことに。定期的なケアが必須です」と、川上さんは言います。
【退治法】
洗濯できるタイプは表示に従い、洗濯機で洗うかクリーニングに出します。ただし、カビ汚れが広範囲のものは、リカバリーは困難。新しいものと交換しましょう。
【予防法】
掃除のときはカーテンにも掃除機をかけ、付着したホコリを吸い取ります。半年に一度、洗濯するかクリーニングに出し、全体の汚れを落としてください。
<壁>カビが発生したら殺菌以外手はなし。家具は壁から離して
「ふいても汚れが取れなくて」とHさんが放置していた壁からはアレルギーの原因となるクロカビが720個も検出され、大ショック。
壁紙に薄く黒いカビ汚れを発見。
「このままではカビの胞子が拡散する心配が…」という川上さんに対し、「カビが浮遊する空間で子どもを寝かせていたんですね…」とHさんは反省しきり。色は残りますが、消毒用エタノールで殺菌をするのがオススメです。
【退治法】
ナイロン製の壁紙なら布+消毒用エタノールで殺菌が可能。ただし、布製の場合は、シミになる可能性が。素材がわからない場合はすみの方で試してみてください。
【予防法】
壁にもホコリがつくので、定期的に払い落とします。結露があるときは、こまめにふき取って。北側の部屋は換気をよくし、家具を壁から少し離して置くとカビ予防になります。
<クローゼット>綿ボコリがたまり、空気がよどむとカビ発生の危険大
クローゼットの中は、繊維くずなどがたまることで想像以上にホコリが。「扉を閉めきっていると湿った空気がよどんでいることも」。大切な衣類を傷めないためにも早めのカビ対策が必要です。
【退治法】
壁面やすみにカビが生えたら、中のものを取り出してから退治を。消毒用エタノール+布でカビを押さえるようにふいたあと、水でかたく絞った布でふき、換気します。
【予防法】
衣類はホコリや湿気を飛ばしてからしまう習慣に。定期的に掃除機でクローゼット内のホコリを吸い取り、しばらく扉をあけ放ってよどんだ空気を追い出します。
<枕・ぬいぐるみ>日々の汚れがダニの原因に。洗濯+天日干しで対策を
枕からは、ホコリ1g当たりコナヒョウヒダニ86匹、ヤケヒョウヒダニ121匹を検出。これには、「二男が花粉症なので気をつけます」とHさんはびっくり。
皮脂がつきやすい枕、手アカで汚れがちなぬいぐるみは、油断するとダニの温床に。「手肌に触れるものだけに心配です」と不安そうなHさんに、「ダニアレルゲンは水洗いで取り除くことができます。洗濯できるものを選び、こまめにケアするといいですよ」と川上さんはアドバイスします。
【退治法】
水洗い可のものは洗濯→天日干し。不可のものは天日干しを徹底します。その後、どちらも布団用ノズルをつけた掃除機でダニを残さず吸い取ります。
【予防法】
枕はカバーをまめに交換し、本体も定期的にケアを。ぬいぐるみは重曹と一緒にビニール袋に入れてよく振り、掃除機でホコリを吸い取る方法もオススメです。
※本記事はESSE2015年7月号の記事を抜粋したものです